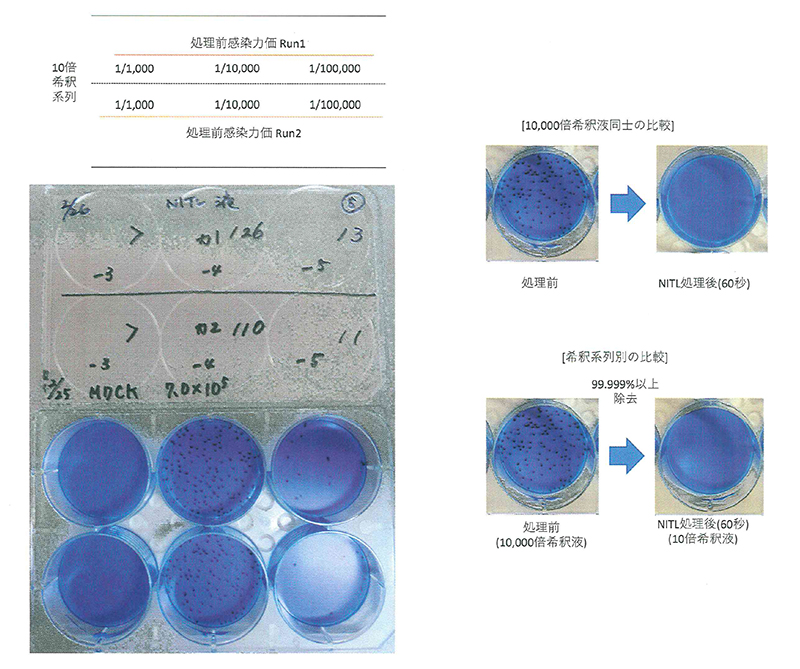

臭い・ウイルス・菌を99.9%除去
ウイルス・菌に効果を発揮します
NITL(ニトル)の安定化二酸化塩素は特殊な製法からつくられています。菌やウイルスが存在する時のみ、弱酸性純水の中に溶け込んでいる二酸化塩素が必要な量だけ発生し反応する【要時生成型二酸化塩素】です。今まで消臭できなかった洗濯物の生乾きの臭い、タバコの臭い、車内の臭い、ペットのトイレ臭、靴やブーツの中、足やワキ等の体臭を消臭


NITLの用途
【消臭】今まで困難とされてきた臭い:洗濯物の生乾きの臭い、タバコの臭い、車内の臭い、ペットのトイレ臭、靴やブーツの中、足やワキ等の体臭等。その他:室内(居間や寝室)、衣類、トイレ、便座、介護用品、ペットおよびペット周辺、吐しゃ物、排泄物、生ゴミ、タバコの臭い、エアコンフィルター等。
【除菌・ウイルス除去】吐しゃ物、排泄物、介護用品、サニタリー用品、キッチン用品、室内、トイレ、ペット用品、生ゴミ、床面、壁面等。
【カビ対策】水まわり、エアコンフィルター、浴室、押入れ、床面、壁面等。
【効果を発揮しないもの】芳香剤や香水など化学的に合成された匂い及びゴム等の素材臭には効果を発揮しません。
| 品名 | 除菌消臭剤 |
| 内容成分 | 安定化二酸化塩素、弱酸性純水 |
| 内容量 | 200ml / 300ml / 500ml |
| 使用方法 | ①本品を原液のままスプレー噴霧。 ②しばらく風通しの良い場所で乾かす。 ※臭いが常識を超えて強い場合は同じ作業を繰り返して下さい。 |
ニトル除菌消臭剤の抗インフルエンザウイルス活性の評価
株式会社プロテクティア阪大ラボによるインフルエンザウイルスへの不活化効果の評価
【試験概要】
上記溶液のインフルエンザウイルスへの不活化効果を評価する。
【試験対象菌株・細胞・ウイルス株】
Influenza virus H1N1 A/PR/8/34 宿主細胞:MDCK 細胞(イヌ腎細胞)ATCC VR-1469 ATCC CCL-34

[試験方法]
ITL(ニトル)除菌消臭剤を1.08mLをチューブに分注後、滅菌水を用いて事前調製した各種ウイルス溶液(1-8 x 107pfu/mL)を0.12 mL混合し、撹拌したものを試験液とした。試験液は室温下で静置し、反応を行った。所定時間(60秒、180秒)経過ごとに試験液から0.12 mL溶液を回収し、SCDLP培地1.08 mLと混合した。SCDLP培地による希釈を複数回繰り返し、10倍段階希釈系を作成した。10倍段階希釈液を事前に播種し準備した宿主細胞に1mL滴下し、37°C5%CO.下で1時間感染処理を行った。ウイルス感染後、細胞上清を0.8%オキソイド寒天溶液に置換し、37°C5%CO,下で2日間培養した。プラークの形成を目視で確認した後、5%グルタルアルデヒド溶液で固定し、メチレンブルー染色を行い、形成されたプラーク数の測定データを元にウイルス感染力価を測定した。本試験は2回実施し、2回の平均値を元にNITL除菌消臭剤による不活化率を評価した。
[試験内容一覧]
使用ウイルスインフルエンザウイルスA/PR/8/34(作用時1-5x100pfu/mL)処理時間 60秒、180秒

[試験結果]
インフルエンザウイルス不活化活性
[考察及び結論]
NITL(ニトル)除菌消臭剤のインフルエンザウイルスに対する不活化効果を評価した。インフルエンザウイルスにはHIN1血清型のA/PR/8/34株を用いた。NITL除菌消臭剤は60秒、180秒の処理によって99.999%以上のウイルス不活化効果が確認された。
安定化二酸化塩素について
殺菌には通常塩素や次亜塩素酸ソーダが使われていますが、特有の臭いがあっていつまでも消えず、アルカリ中で有機物と反応して発ガン性物質であるトリハロメタンを生成する、等の欠点があります。水道水の殺菌にも使われていますが、体内に入るものなので欧米では塩素の代わりに二酸化塩素が使われつつあります。二酸化塩素が諸外国で積極的に導入されている大きな要因です。二酸化塩素は、塩素剤と異なり高PH領域でも優れた酸化殺菌効能を発揮しますので塩素剤の効果低減が心配されるアルカリ水質の温浴施設でも安心して利用できます。レジオネラ菌が24時間風呂や温泉に生息し、普段は悪さをしないのですが老人等の体力が劣っている人に感染し、肺炎を引き起こして集団で亡くなる事故があり、厚労省は保健所を通じてレジオネラ菌の対策を徹底するよう指導しています。しかし配管中には微生物が作るバイオフィルムが形成され、従来の塩素では水は殺菌できてもバイオフィルム中の微生物の殺菌は十分出来ません。二酸化塩素には微生物の細胞膜を破壊する機能があるのでバイオフィルムの除去が可能で、塩素による殺菌が塩素化殺菌であるのに対し二酸化塩素は酸化殺菌です。
二酸化塩素が塩素に比べて
- すぐ分解してしまうので毒性が少なく
- 塩素のような強烈な臭いがしない
- 単位重量当たりの殺菌力が塩素より3倍近く優れ
- 消臭等にも有効である
- トリハロメタンが発生しない等の長所があります。
- 殺菌スピードが速い
- PHに左右され難い
- 高い物質浸透性をもつ。
そんな折、アメリカのエンゲルハード社がその表面化学と触媒の技術を駆使して固形二酸化塩素を開発しました。これは多孔質の粉末の表面に亜塩素酸ナトリウム(NaCIO2)と酸を吸着させ、水に触れると反応して二酸化塩素を生成するもので空気中の水分でも反応して空気中に二酸化塩素を放出します。今まで液体を使わなければいけなかったのに一定量の対象水に一定量の錠剤や粉末を溶かせば一定の濃度の二酸化塩素を作ることが出来ます。密封しておけば劣化することなく在庫が可能です。輸送は密封された錠剤または粉末なので容易です。
二酸化塩素水溶液の濃度低下の大きな要因の一つが「揮発」ですが、S-PRO・SPRAYは受注生産体制にて、余剰空間の乏しい密閉容器でお届けしているので濃度低下はほとんどありません(輸送テスト済み)アメリカではハリケーンや津波等の緊急時の飲料水の消毒、歯科医のうがい用水への使用(殺菌と口臭の除去)、医療施設の清掃用等に環境局(EPA)の承認を受けています。アメリカで最も優れた病院の一つに数えられるジョンズポプキンス病院などの論文によれば、少なくとも二酸化塩素は塩素に対して10倍以上の効果があるとされ、細菌やウィルスなどへの高い効果により、より厳しい水準の衛生管理が求められる病院などの院内感染予防や飲料水の消毒などに用いられています。(FDA)アメリカ食品医薬品局などの資料では、多くの悪臭の除去に有効であり水の異臭味の除去や、メチルメルカブタン、トルエンなどの悪臭に優れた消臭効果やシックハウス症候群の原因であるアセトアルデヒドも分解し、対応するカルボン酸にすることがわかっています。WHOやEPA(アメリカ環境保護局)などは、二酸化塩素は塩素よりも低濃度、短い接触時間によりアメーバなどの原生生物に対して有効であると国際機関で確認されています。EPAや国際ガン調査機関の発がん性評価はマイナスになっています。発がん性のあるトリハロメタン類を生成する問題もありません。EPAがアメリカ炭素菌事件で二酸化塩素ガスで殺菌して安全宣言を出しました。アメリカ・カリタス・カーニー病院のマイケル・バーザ博士は「二酸化塩素に退治できないものはないと言ってもいい。今まで試されたすべてのウィルスや細菌が死滅したほか、菌類や寄生虫までもが一掃されている」「二酸化塩素は、それぞれの微生物に対して違った形で効果を発揮する。細菌に触れば細胞膜を破壊し、ウィルスではウィルス自体を変性させる、ウィルスを爆発させてしまうのだ-まるで小さな核爆弾のようだ」「細菌はすぐに死滅し始めた、たった1分で2ログ(100分の1)にまで減少したのだ。細菌の数は時間が経っても着実に減り続け20分後には、バクテリアの99.99%が死滅した」とバーザ博士は言っている
二酸化塩素安全性認定
| 二酸化塩素安全性認定 | ADI(人体摂取許容基準) Aクラス認定 |
| FDA(米国食品医療品省) | 食品添加物、医療用消毒 飲料水、工場廃棄物処理 |
| NASA(米国航空宇宙局) | スペースシャトル内及び宇宙食の完全滅菌 食中毒発生危険度の高い |
| HACCP(米国食中毒予防計画) | 食肉消毒に採用 飲料水の酸化、消毒 小麦粉の漂白 |
| 厚生労働省 | プール、公衆浴場水 消毒、一般抗菌 消毒に使用許可 |
| 経済産業省 | 消防法及び劇薬物取締法・・・指定外 |
安定化二酸化塩素の安全性・安定化は世界の公的認定を受けています。
- 日本厚生労働省………飲料水の殺菌、小麦粉の漂白、プール・公衆浴場の水の殺菌、一般抗菌殺菌に使用可。カット野菜、フルーツには食品添加物として認められています。
- 日本経済産業省………消防法及び劇毒物取締法指定除外
- 国連食品添加物専門委員会………人体摂取許容基準(ADI)で砂糖・塩と同クラス(JECFA)のA-1クラス認定
- 米国食中毒予防計画………食中毒発生危険度の高い食品消毒に公式採用
- 米国食品医薬品省(FDA)………医薬品、医薬部外品、食品添加物、医療用消毒、医認証療用機器消毒許可
- 米国環境保護局(EPA)………飲料水、工場排水処理、環境浄化用に使用許可認証
- 米国農務省(USDA)
- 使用可能規格(P-1,D-3,G-5)………食品、食品消毒使用許可
- 米国食品安全検査局(FSDA)………食品、食品消毒使用許可
- 米国航空宇宙局(NASA)………スペースシャトル内及び宇宙食の完全滅菌採用


